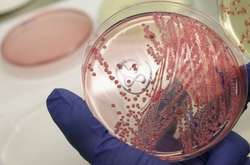
У Білорусі виявили сибірську виразку

На Херсонщині гадюка вкусила 12-річну дівчинку

12-річну дівчинку на острові Джарилгач за ногу вкусила гадюка
Сьогодні вранці на острові Джарилгач у Херсонській області 12-річну дівчинку за ногу вкусила гадюка. Про це повідомив головний лікар КЗ «Обласний територіальний центр екстреної медичної допомоги та медицини катастроф» Херсонської обласної ради Юрій Бовкун, пише УНН.
Бовкун розповів, що повідомлення про те, що 12-річну дівчинку на острові Джарилгач за ногу вкусила гадюка, надійшло о 9:58.
Також, він розповів, що дівчинку госпіталізували до Скадовської центральної районної лікарні, до хірургічного відділення у стані середнього ступеня тяжкості.
Нагадаємо, за минулу добу через укуси змій у лікарні опинилися четверо людей з одного й того ж району Львівської області. Усі постраждалі отримали укуси змій у Сколівському районі. Обставини подій встановлюються.
Нагадаємо, напередодні жінка на Львівщині потрапила у лікарню через укус змії.
Що робити, якщо вас вкусила змія?
У разі укусу змії намагайтесь якнайшвидше потрапити до лікаря. Лише професійний медик зможе надати необхідну допомогу. Якщо транспортування до лікарні довготривале, постраждалий потребує домедичної допомоги:
• Зберігайте спокій і стежте, щоби постраждалий менше рухався;
• Звільнійть уражену частину тіла від одягу, взуття, прикрас тощо;
• На місце укусу накладіть стерильну пов’язку з антисептиком;
• Дайте постраждалому воду - при укусі змії важливо багато пити;
• Якщо є аптечка, дайте постраждалому 1-2 таблетки ліків від алергії;
• При транспортуванні покладіть уражену кінцівку на підвищення;
• Якщо є така можливість, прикладіть до рани лід, обгорнутий у тканину.
Чого не варто робити при укусі змії:
• Не намагайтесь обробляти рану додатково;
• Не припікайте рану;
• Не накладайте джгут;
• Не висмоктуйте отруту: таким чином вірогідність зараження збільшується, до того ж небезпеці піддається й людина, у якої отрута опинилась у роті. Відсмоктувати отруту можна тільки у тому випадку, якщо в найближчі години неможливо отримати медичну допомогу;
• Не вживайте алкоголь.

Коментарі — 0